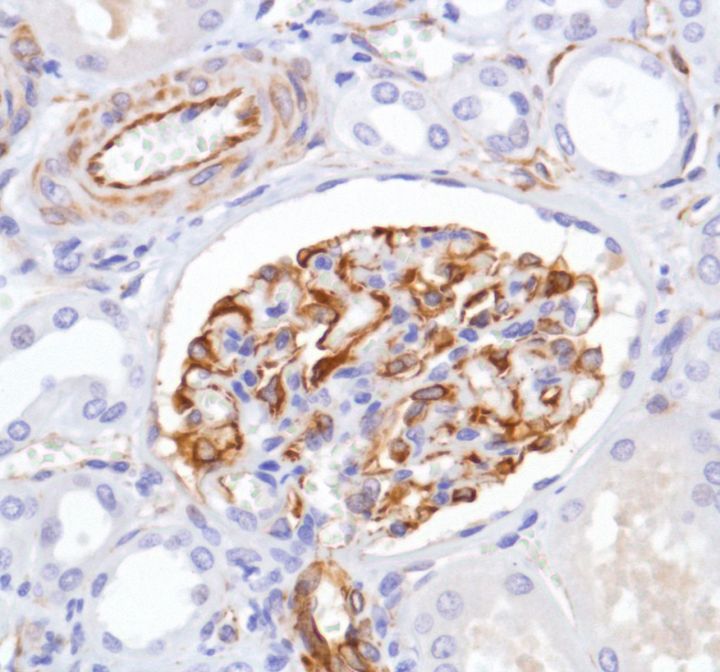

Nestin (SP103)
Nestin is a class VI intermediate filament expressed in the developing central nervous system (CNS) in early embryonic neuroepithelial stem cells. This protein has been widely used as a predominant marker for stem / progenitor cells, glioma cells, and tumor endothelial cells in the mammalian CNS. Furthermore, it is a superior angiogenic marker to evaluate neovascularity of endothelial cells in tumor.
....Related Files